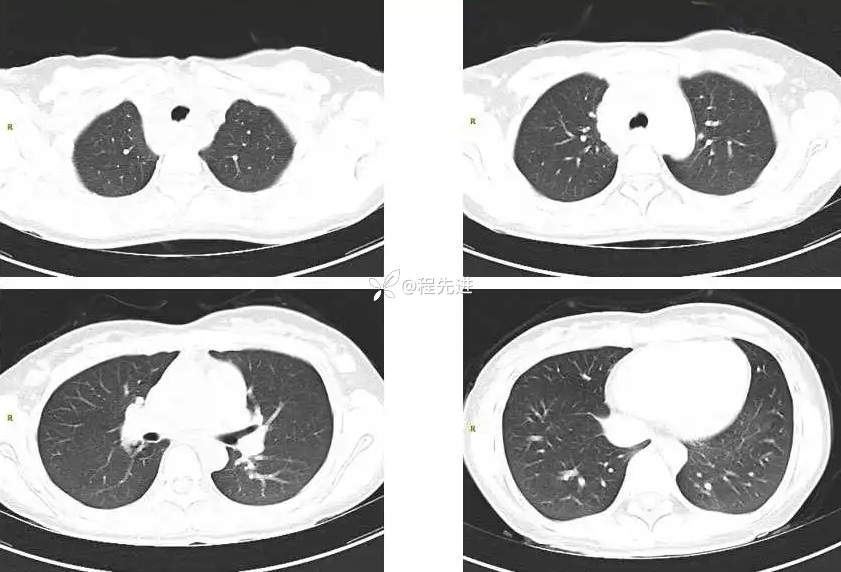
img

【心胸】特别精彩病例|体检发现纵隔肿块1月余,纵隔占位期待您的精彩解读!

病例信息
患者性别:女
患者年龄:23岁
主 诉:体检发现纵隔肿块1月余
现病史:患者1月前体检发现纵隔肿块。病程中无发热寒战,无咳嗽咳痰,无头痛头晕,无恶心呕吐。患者精神睡眠可,二便正常,体重未见明显异常下降。
既往史、家族史及个人史:(-)
CT平扫+增强:

MRI平扫+增强:
T1、T1增强:

DWI、ADC:

3期增强:

期待您的点赞支持!
期待您的精彩解读!
最后编辑于 2024-05-15 · 浏览 1069
病例信息
患者性别:女
患者年龄:23岁
主 诉:体检发现纵隔肿块1月余
现病史:患者1月前体检发现纵隔肿块。病程中无发热寒战,无咳嗽咳痰,无头痛头晕,无恶心呕吐。患者精神睡眠可,二便正常,体重未见明显异常下降。
既往史、家族史及个人史:(-)
CT平扫+增强:
MRI平扫+增强:
T1、T1增强:
DWI、ADC:
3期增强:
期待您的点赞支持!
期待您的精彩解读!
最后编辑于 2024-05-15 · 浏览 1069